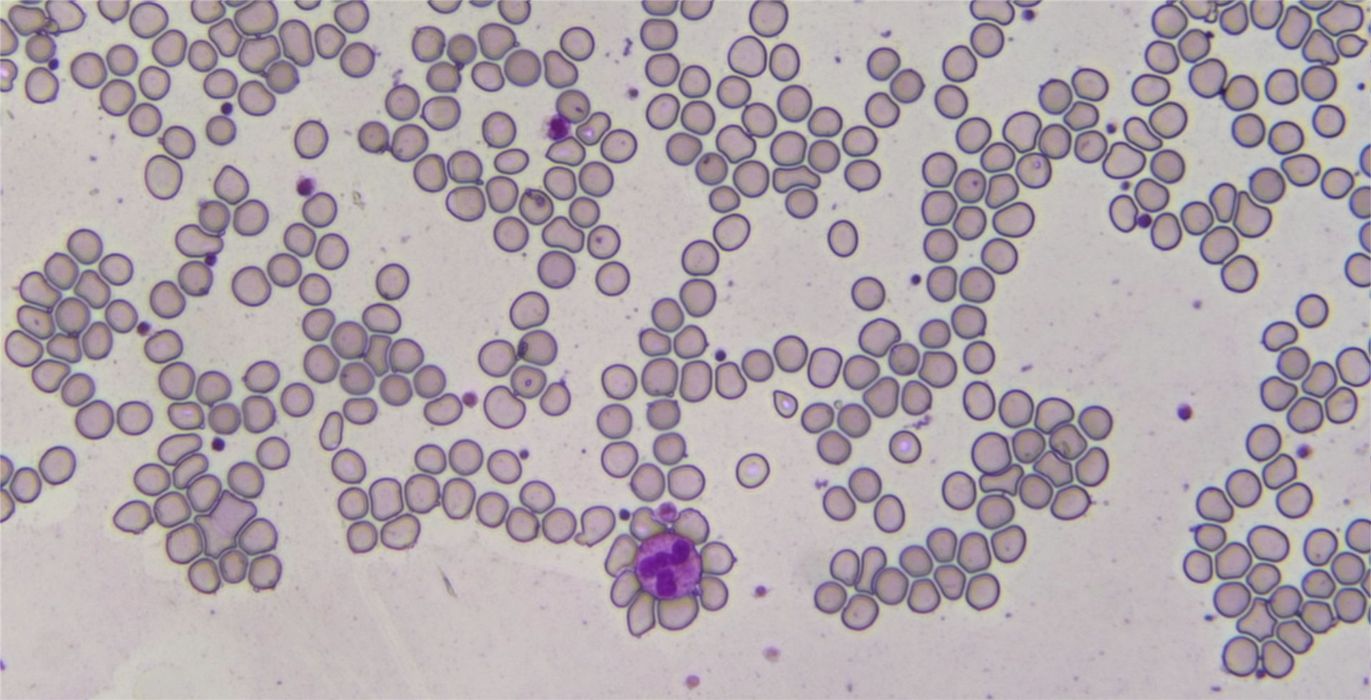

Retina Display for HD Series cameras
by Tucsen
Original price
$995.00
-
Original price
$995.00
Original price
$995.00
$995.00
-
$995.00
Current price
$995.00
Retina Display (Camera NOT Included)
The newly designed and innovative Retina Display is a High Resolution Tablet PC produced by leading scientific camera manufacturer Tucsen.
Compatible with the following HD Cameras:
The HD Lite Retina Display is an impressive digital microscope tablet with:
- Dual-core 1.5GHz CPU
- 1G DDR3 Memory
- Colour 1920×1080 HD Display
- Capture Resolution 2592×1944
- Intelligent Operation
High Quality HD Screen
Adding one of our HD microscope cameras, the HD-Lite Retina Display offers a high resolution screen (1920×1080), with great colour fidelity and smooth, crisp images. The 5-point multi-touch screen, gives you ease of use with the same quality as an Apple iPad.
Significant improvements in screen quality give you greater brightness. This, coupled with IPS technology, designed specifically to reduce light reflection, gives you sharp clear images from any angle.